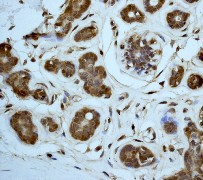

> Antigen, Antibodies, ELISA, Western Blot > Primary Antibody > Monoclonal Antibodies > MAPK1 Antibody (C-term)Brand |
Leading Biology | Catalog Number |
APR08322G |
Product Type |
Monoclonal Antibodies | Field of Research |
|
Product Overview |
We constantly strive to ensure we provide our customers with the best antibodies. As a result of this work we offer this antibody in purified format.
We are in the process of updating our datasheets. If you have any questions regarding this update, please feel free to contact our technical support team.
This product is a high quality MAPK1 antibody (C-term).
|
||
Molecular Weight |
41390 Da
|
||
Cellular Localization |
Antigen Cellular Localization:
Cytoplasm, cytoskeleton, spindle. Nucleus. Cytoplasm, cytoskeleton, microtubule organizing center, centrosome. Cytoplasm. Note=Associated with the spindle during prometaphase and metaphase (By similarity). PEA15- binding and phosphorylated DAPK1 promote its cytoplasmic retention. Phosphorylation at Ser- 246 and Ser-248 as well as autophosphorylation at Thr-190 promote nuclear localization
|
||
Host |
Rabbit
|
||
Species Reactivity |
Human, Mouse, Rat
|
||
Target |
A synthetic peptide corresponding to residues near the C-term of human ERK2 p42 MAPK was used as immunogen.
|
||
Clone |
E460
|
||
Symbol |
ERK2, PRKM1, PRKM2
|
||
GeneID |
|||
UniProt ID |
|||
Function |
Serine/threonine kinase which acts as an essential component of the MAP kinase signal transduction pathway. MAPK1/ERK2 and MAPK3/ERK1 are the 2 MAPKs which play an important role in the MAPK/ERK cascade. They participate also in a signaling cascade initiated by activated KIT and KITLG/SCF. Depending on the cellular context, the MAPK/ERK cascade mediates diverse biological functions such as cell growth, adhesion, survival and differentiation through the regulation of transcription, translation, cytoskeletal rearrangements. The MAPK/ERK cascade plays also a role in initiation and regulation of meiosis, mitosis, and postmitotic functions in differentiated cells by phosphorylating a number of transcription factors. About 160 substrates have already been discovered for ERKs. Many of these substrates are localized in the nucleus, and seem to participate in the regulation of transcription upon stimulation. However, other substrates are found in the cytosol as well as in other cellular organelles, and those are responsible for processes such as translation, mitosis and apoptosis. Moreover, the MAPK/ERK cascade is also involved in the regulation of the endosomal dynamics, including lysosome processing and endosome cycling through the perinuclear recycling compartment (PNRC); as well as in the fragmentation of the Golgi apparatus during mitosis. The substrates include transcription factors (such as ATF2, BCL6, ELK1, ERF, FOS, HSF4 or SPZ1), cytoskeletal elements (such as CANX, CTTN, GJA1, MAP2, MAPT, PXN, SORBS3 or STMN1), regulators of apoptosis (such as BAD, BTG2, CASP9, DAPK1, IER3, MCL1 or PPARG), regulators of translation (such as EIF4EBP1) and a variety of other signaling-related molecules (like ARHGEF2, DCC, FRS2 or GRB10). Protein kinases (such as RAF1, RPS6KA1/RSK1, RPS6KA3/RSK2, RPS6KA2/RSK3, RPS6KA6/RSK4, SYK, MKNK1/MNK1, MKNK2/MNK2, RPS6KA5/MSK1, RPS6KA4/MSK2, MAPKAPK3 or MAPKAPK5) and phosphatases (such as DUSP1, DUSP4, DUSP6 or DUSP16) are other substrates which enable the propagation the MAPK/ERK signal to additional cytosolic and nuclear targets, thereby extending the specificity of the cascade. Mediates phosphorylation of TPR in respons to EGF stimulation. May play a role in the spindle assembly checkpoint. Phosphorylates PML and promotes its interaction with PIN1, leading to PML degradation.
|
||
Summary |
Extracellular signal regulated kinase 2 (ERK 2) also known as maturation or mitogen activated protein kinase (MAPK) is involved in eukaryotic signal transduction (1) . Activated by a dual phosphorylation on threonine and tyrosine residue by the dual-specificity kinase MKK1/2, ERK2 p42 translocate to the nucleus after stimulation (2). Once phosphorylated, ERK2 can form dimers with phosphorylated and unphosphorylated ERK2 partners. It is also able to phosphorylate multiple substrates such as EGFR, c-PLA2, Elk1/TCF and c-Myc (3-5).
|
||
Form |
50 mM Tris-Glycine (pH 7.4), 0.15 M NaCl, 40% Glycerol, 0.01% sodium azide and 0.05% BSA. |
||
Storage & Stability |
Store at +4°C short term. For long-term storage, aliquot and store at -20°C or below. Stable for 12 months at -20°C. Avoid repeated freeze-thaw cycles.
|
||
Applications |
WB, IHC
|
||
Dilution |
WB~~1:1000~5000
IHC~~1:250~500
|
||
Synonyms |
Mitogen-activated protein kinase 1, MAP kinase 1, MAPK 1, ERT1, Extracellular signal-regulated kinase 2, ERK-2, MAP kinase isoform p42, p42-MAPK, Mitogen-activated protein kinase 2, MAP kinase 2, MAPK 2, MAPK1, ERK2, PRKM1, PRKM2
|
||
Images |

A. Western blot analysis on A431 cell lysate using anti-ERK2 p42 MAPK (C-term) RabMAb (Cat. APR08322G), 1:2,000 dilution
B. Immunohistochemical analysis of paraffin-embedded human breast carcinoma using anti- ERK2 p42 MAPK (C-term) RabMAb (Cat. APR08322G). |
||
Specification |
|||
Quantity |
|
||
| Select | Brand | Catalog No. | Product Name | Pack Size | Type | Field of Research | Specification | Quantity | Price(USD) | |
| 1 | Leading Biology | APG02467G | CCK4 / PTK7 Antibody (clone 4F9) | 50 μl | Monoclonal Antibodies |
|
$495.00 | Add Ask | ||
| 2 | Leading Biology | AMM04683G | GALT Antibody (clone 4C11) | 50 μg | Monoclonal Antibodies |
|
$545.00 | Add Ask | ||
| 3 | Leading Biology | AMM01402G | Vimentin (Mesenchymal Cell Marker) Antibody - With BSA and Azide | 50 ug | Monoclonal Antibodies |
|
$395.00 | Add Ask | ||
| 4 | Leading Biology | APR08280G | LTA4H / LTA4 Antibody (clone 9G8) | 50 μl | Monoclonal Antibodies |
|
$495.00 | Add Ask | ||
| 5 | Leading Biology | AMM00172G | CD1a / HTA1 (Mature Langerhans Cells Marker) Antibody - With BSA and Azide | 50 ug | Monoclonal Antibodies |
|
$395.00 | Add Ask | ||
| 6 | Leading Biology | AMM05750G | CEBPA Antibody | 100 μl | Monoclonal Antibodies |
|
$545.00 | Add Ask |
 Leading Biology Inc.
2600 Hilltop DR, Building G, B Suite C138
Richmond, CA, 94806
Tel: 1-661-524(LBI)-0262
Email: info@leadingbiology.com
Leading Biology Inc.
2600 Hilltop DR, Building G, B Suite C138
Richmond, CA, 94806
Tel: 1-661-524(LBI)-0262
Email: info@leadingbiology.com
Complete this form and click send to ask us a question, request a quote or simply say hello.

You have 0 item in your cart

You have 0 item in your inquiry list
